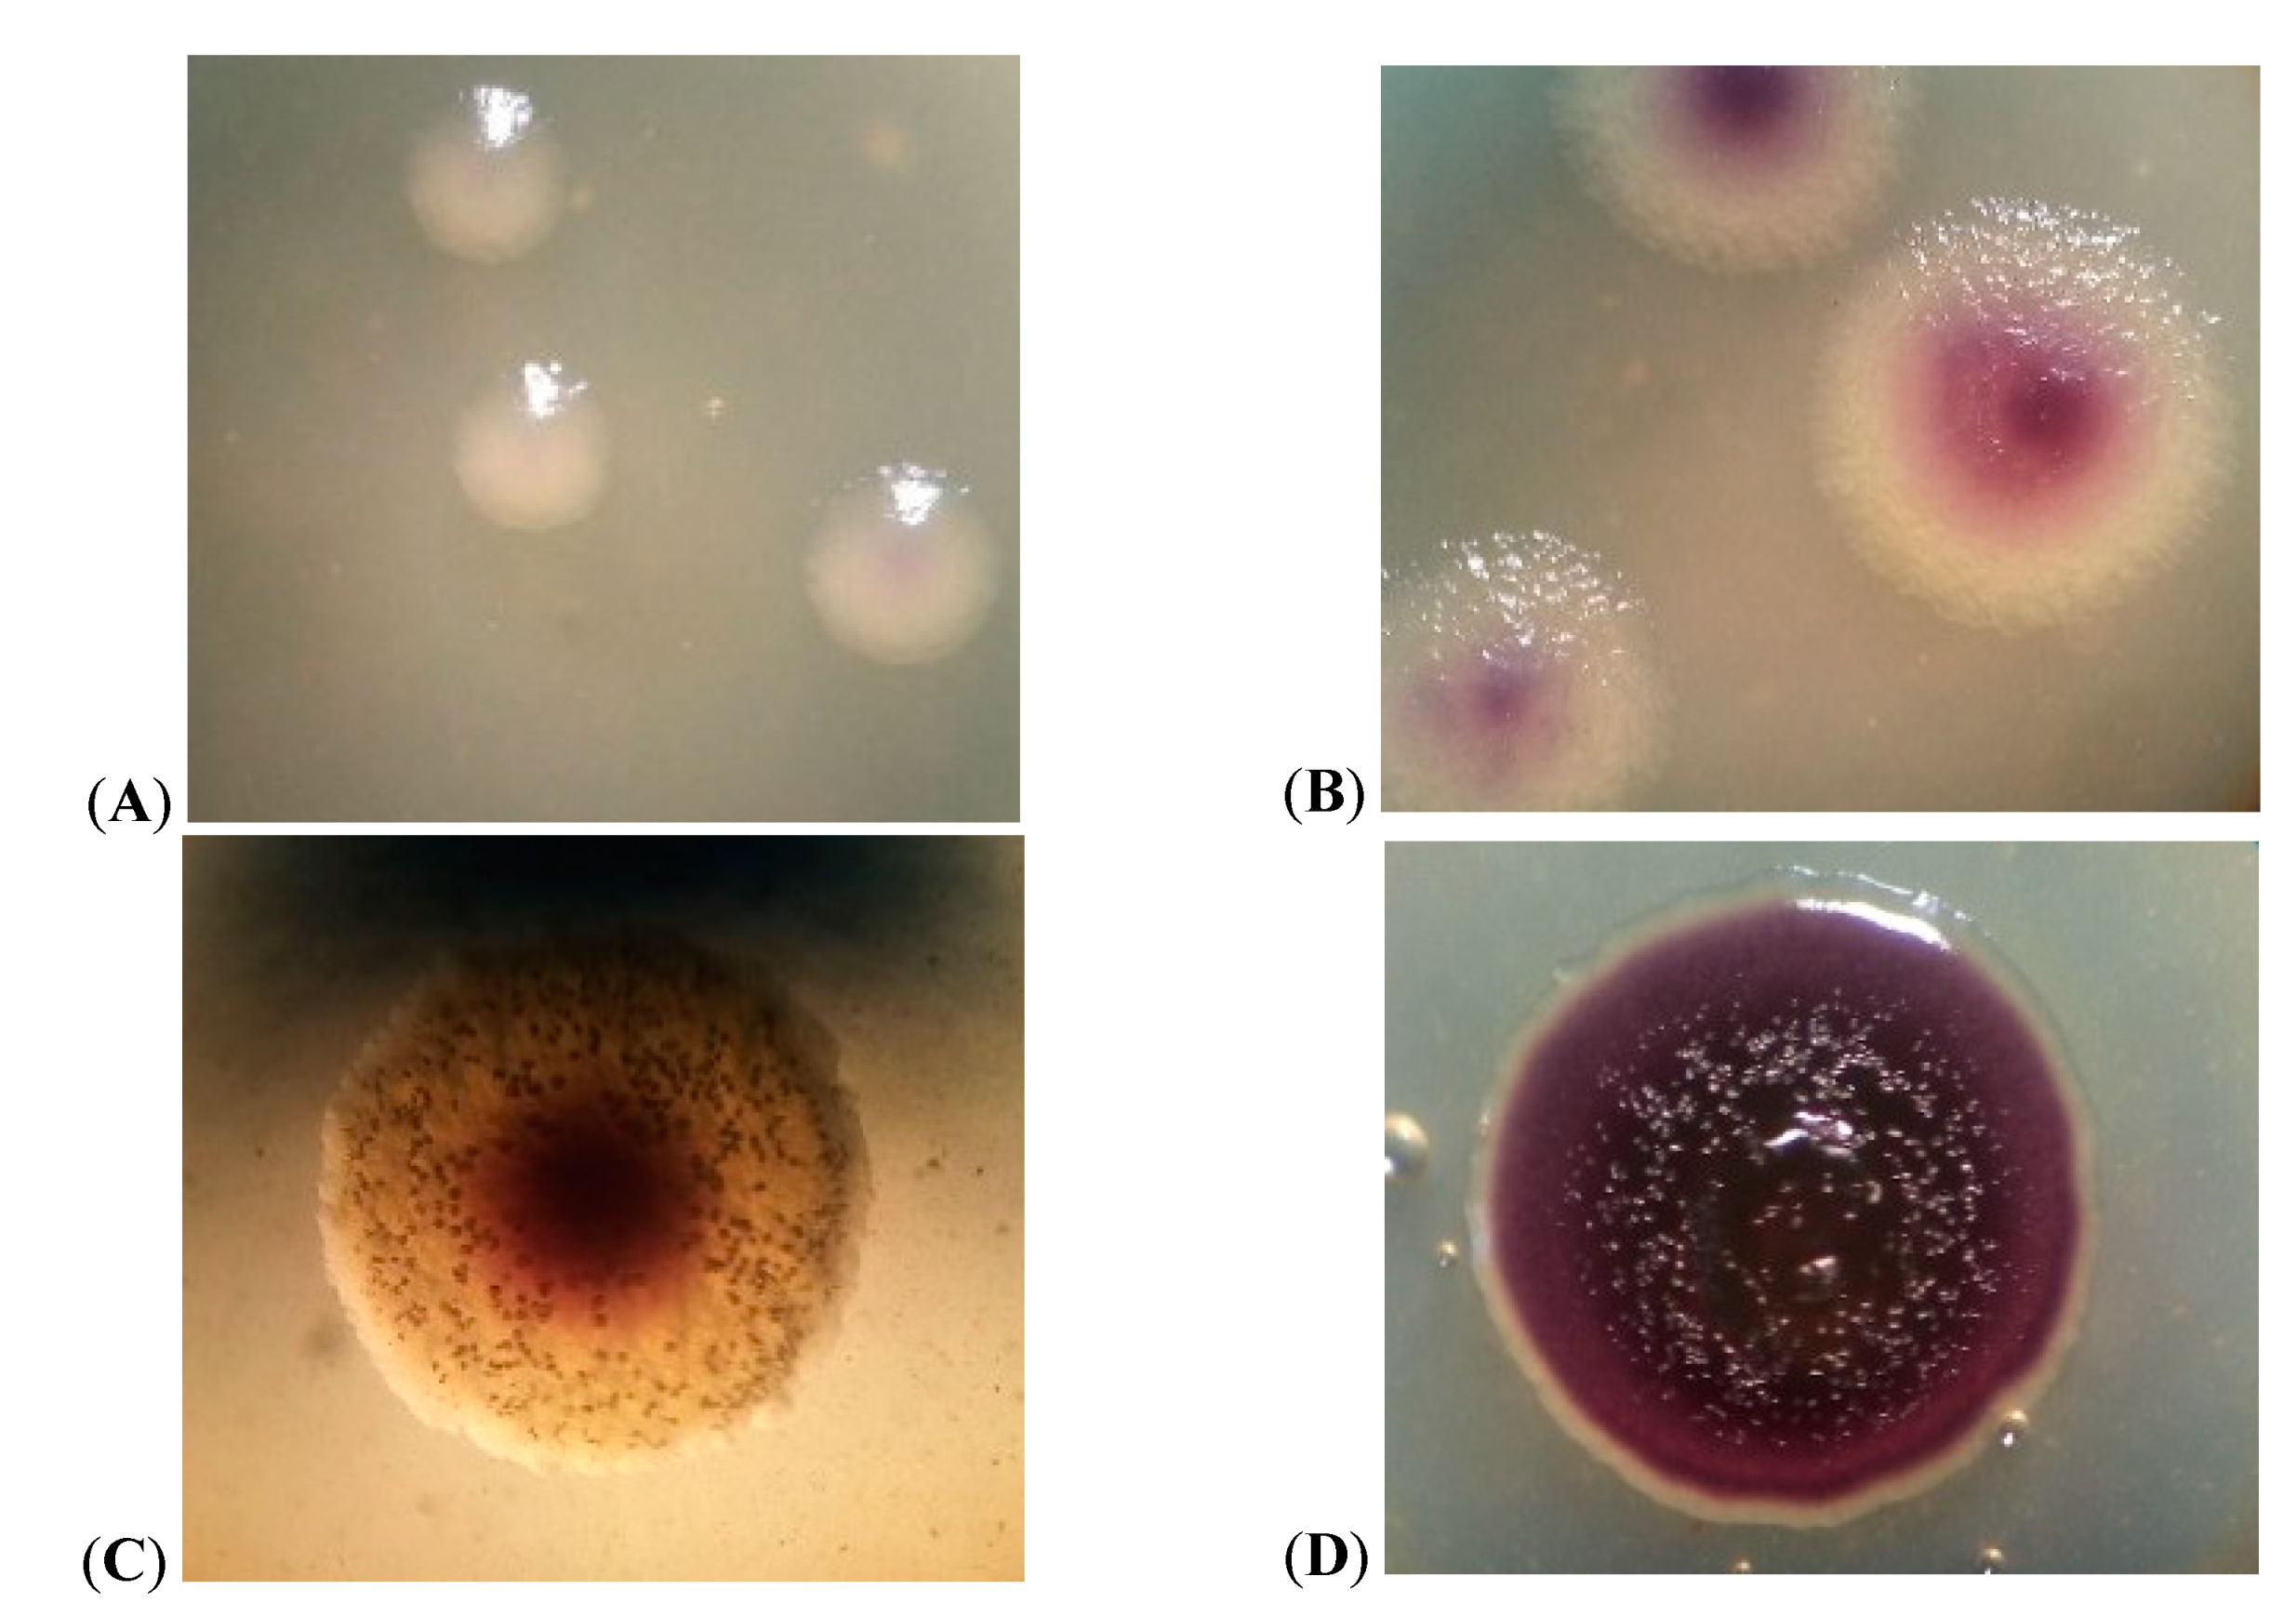
Microorganisms 09 00102 g002 Microorganisms 09 00102 g002

A Blue-Purple Pigment-Producing Bacterium Isolated from the Vezelka River in the City of Belgorod
Abstract
1. Introduction
2. Materials and Methods
2.1. Strain
2.2. Morphology, Culture Media, and Growth Conditions
2.3. Microscopy
2.3.1. Light Microscopy
2.3.2. Electron Microscopy of Ultrathin Sections
2.4. Biochemical Characteristics
2.5. Resistance to Antibiotics
2.6. The Ability of the JF4 Strain to Control the Growth of Various Microorganisms
2.7. Phylogenetic Analysis
2.8. Pigment Extraction
3. Results and Discussion
3.1. Cell Morphology
3.2. Physiological and Biochemical Characteristics of the Strain
3.3. Growth Characteristics of JF4 Strain
3.4. Antimicrobial Activity
3.5. Antibiotic Resistance
4. Conclusions
Author Contributions
Funding
Data Availability Statement
Acknowledgments
Conflicts of Interest
References
- Schlegel, G. General microbiology: Translation from German. Mir 1987, 567, 273. [Google Scholar]
- Bayram, S.; Dengiz, C.; Gerçek, Y.C.; Cetin, I.; Topcul, M.R. Bioproduction, structure elucidation and in vitro antiproliferative effect of eumelanin pigment from Streptomyces parvus BSB49. Arch. Microbiol. 2020, 202, 1–9. [Google Scholar] [CrossRef] [PubMed]
- Akhmedova, F.R.; Jafarova, U.D. Studying the distribution of pigment-forming bacteria in various substrates. Actual Probl. Humanit. Nat. Sci. 2012, 12, 26–29. [Google Scholar]
- Egorov, N.S. Fundamentals of the Doctrine of Antibiotics: A Textbook for Students of Biological Specialties of Universities, 4th ed.; Revised and Enlarged; Nauka: Moscow, Russia, 1986; 448p. [Google Scholar]
- Justo, G.Z.; Durán, N.; Ferreira, C.V.; Melon, P.S.; Cordi, L.; Martins, D. Violacein: Properties and biological activities. Biotechnol. Appl. Biochem. 2007, 48, 127–133. [Google Scholar] [CrossRef]
- Marinelli, F.; Genilloud, O.; Fedorenko, V.; Ron, E.Z. Specialized bioactive microbial metabolites: From gene to product. BioMed Res. Int. 2015, 2015, 276964. [Google Scholar] [CrossRef]
- Im, H.; Choi, S.Y.; Son, S.; Mitchell, R.J. Combined Application of Bacterial Predation and Violacein to Kill Polymicrobial Pathogenic Communities. Sci. Rep. 2017, 7, 1–10. [Google Scholar] [CrossRef]
- Kido, M.; Idogaki, H.; Nishikawa, K.; Omasa, T. Violacein improves recombinant IgG production by controlling the cell cycle of Chinese hamster ovary cells. Cytotechnology 2020, 1–14. [Google Scholar] [CrossRef]
- Hui, C.; Guo, Y.; Liu, L.; Zhang, N.-X.; Gao, C.-X.; Yang, X.-Q.; Yi, J. Genetic control of violacein biosynthesis to enable a pigment-based whole-cell lead biosensor. RSC Adv. 2020, 10, 28106–28113. [Google Scholar] [CrossRef]
- Wang, H.S.; Wang, F.Z.; Zhu, X.F.; Yan, Y.C.; Yu, X.H.; Jiang, P.X.; Xing, X.H. Biosynthesis and characterization of violacein, deoxyvi-olacein and oxyviolacein in heterologous host, and their antimicrobial activities. Biochem. Eng. J. 2012, 67, 148–155. [Google Scholar] [CrossRef]
- Netrusov, A.I.; Egorova, M.A.; Zakharchuk, L.M. Practical Course on Microbiology; Netrusova, A.I., Ed.; Academy: Moscow, Russia, 2005; 608p. [Google Scholar]
- Snegin, E.A. (Ed.) Practical Book on Biometrics: Study Guide; Publishing House: Belgorod, Russia, 2016; 56p. [Google Scholar]
- Tepper, E.Z.; Shilnikova, V.K.; Pereverzeva, G.I. (Eds.) Practical Book on Microbiology, 2nd ed.; Kolos: Moscow, Russia, 1979; 216p. [Google Scholar]
- Reynolds, E.S. The use of lead citrate at high pH as an electron-opaque stain in electron microscopy. J. Cell Biol. 1963, 17, 208–213. [Google Scholar] [CrossRef]
- Weisburg, W.G.; Barns, S.M.; Pelletier, D.A.; Lane, D.J. 16S ribosomal DNA amplification for phylogenetic study. J. Bacteriol. 1991, 173, 697–703. [Google Scholar] [CrossRef] [PubMed]
- Aranda, S.; Montes-Borrego, M.; Landa, B.B. Purple-Pigmented Violacein-Producing Duganella sp. Inhabit the Rhizosphere of Wild and Cultivated Olives in Southern Spain. Microb. Ecol. 2011, 62, 446–459. [Google Scholar] [CrossRef]
- Hoult, J.; Krieg, N.; Snit, P.; Staley, J.; Williams, S. (Eds.) Bergey’s Guide to Bacteria; Mir: Moscow, Russia, 1997; Volume 1, 432p. [Google Scholar]
- Blackburn, M.B.; Farrar, R.R., Jr.; Sparks, M.E.; Kuhar, D.; Mitchell, A.; Gundersen-Rindal, D.E. Chromobacterium sphagni sp. nov., an insecticidal bacterium isolated from Sphagnum bogs. Taxon. Descr. Int. J. Syst. Evol. Microbiol. 2017, 67, 3417–3422. [Google Scholar] [CrossRef] [PubMed]
- Martin, P.A.W.; Gundersen-Rindal, D.; Blackburn, M.; Buyer, J. Chromobacterium subtsugae sp. nov., a betaproteobacterium toxic to Colorado potato beetle and other insect pests. Int. J. Syst. Evol. Microbiol. 2007, 57, 993–999. [Google Scholar] [CrossRef] [PubMed]
- Young, C.-C.; Arun, A.B.; Lai, W.-A.; Chen, W.-M.; Chao, J.-H.; Shen, F.-T.; Rekha, P.D.; Kämpfer, P. Chromobacterium aquaticum sp. nov., isolated from spring water samples. Int. J. Syst. Evol. Microbiol. 2008, 58, 877–880. [Google Scholar] [CrossRef]
- Han, X.Y.; Han, F.S.; Segal, J. Chromobacterium haemolyticum sp. nov., a strongly haemolytic species. Int. J. Syst. Evol. Microbiol. 2008, 58, 1398–1403. [Google Scholar] [CrossRef]
- Kämpfer, P.; Busse, H.-J.; Scholz, H.C. Chromobacterium piscinae sp. nov. and Chromobacterium pseudoviolaceum sp. nov., from environmental samples. Int. J. Syst. Evol. Microbiol. 2009, 59, 2486–2490. [Google Scholar] [CrossRef]
- Soby, S.D.; Gadagkar, S.R.; Contreras, C.; Caruso, F.L. Chromobacterium vaccinii sp. nov., isolated from native and cultivated cranberry (Vaccinium macrocarpon Ait.) bogs and irrigation ponds. Int. J. Syst. Evol. Microbiol. 2013, 63, 1840–1846. [Google Scholar] [CrossRef]
- Menezes, C.B.A.; Tonin, M.F.; Corrêa, D.B.A.; Parma, M.; De Melo, I.S.; Zucchi, T.D.; Destéfano, S.A.L.; Garboggini, F.F. Chromobacterium amazonense sp. nov. isolated from water samples from the Rio Negro, Amazon, Brazil. Antonie Leeuwenhoek 2015, 107, 1057–1063. [Google Scholar] [CrossRef]
- Zhou, S.; Guo, X.; Wang, H.; Kong, D.; Wang, Y.; Zhu, J.; Dong, W.; He, M.; Hu, G.; Zhao, B.; et al. Chromobacterium rhizoryzae sp. nov., isolated from rice roots. Int. J. Syst. Evol. Microbiol. 2016, 66, 3890–3896. [Google Scholar] [CrossRef]
- Bajaj, A.; Kumar, A.; Yadav, S.; Kaur, G.; Bala, M.; Singh, N.K.; Kumar, R.M.; Manickam, N.; Mayilraj, S. Isolation and characterization of a novel Gram-negative bacterium Chromobacterium alkanivorans sp. nov., strain IITR-71T degrading halogenated alkanes. Int. J. Syst. Evol. Microbiol. 2016, 66, 5228–5235. [Google Scholar] [CrossRef]
- Sparks, M.E.; Farrar, R.R., Jr.; Kuhar, D.; Mowery, J.D.; Mitchell, A.; Gundersen-Rindal, D.E.; Blackburn, M.B. Chromobacterium phragmitis sp. nov., isolated from estuarine marshes. Int. J. Syst. Evol. Microbiol. 2019, 69, 2681–2686. [Google Scholar] [CrossRef]
- Short, S.M.; Van Tol, S.; MacLeod, H.J.; Dimopoulos, G. Hydrogen cyanide produced by the soil bacterium Chromobacterium sp. Panama contributes to mortality in Anopheles gambiae mosquito larvae. Sci. Rep. 2018, 8, 1–13. [Google Scholar] [CrossRef] [PubMed]
- Kimura, H.; Takahashi, T.; Hiraka, H.; Iwama, M.; Takeishi, M. Effective Biosynthesis of Poly(3-hydroxybutyrate) from Plant Oils by Chromobacterium sp. Polym. J. 1999, 31, 210–212. [Google Scholar] [CrossRef]
- Tay, S.B.; Natarajan, G.; Rahim, M.N.B.A.; Tan, H.T.; Chung, M.C.M.; Ting, Y.P.; Yew, W.S. Enhancing gold recovery from electronic waste via lixiviant metabolic engineering in Chromobacterium violaceum. Sci. Rep. 2013, 3, srep02236. [Google Scholar] [CrossRef] [PubMed]
- Logan, N.A. Numerical Taxonomy of Violet-Pigmented, Gram-Negative Bacteria and Description of Iodobacter fluviatile gen. nov., comb. nov. Int. J. Syst. Bacteriol. 1989, 39, 450–456. [Google Scholar] [CrossRef]
- Parker, C.T.; Wigley, S.; Garrity, G.M. Iodobacter fluviatilis corrig. (Moss et al. 1981) Logan 1989; Names for Life, LLC: East Lansing, MI, USA, 2020. [Google Scholar] [CrossRef]
- Logan, N.A. Iodobacter. In Bergey’s Manual of Systematics of Archaea and Bacteria; Whitman, W.B., Rainey, F., Kämpfer, P., Trujillo, M., Chun, J., DeVos, P., Hedlund, B., Dedysh, S., Eds.; Wiley: Hoboken, NJ, USA, 2015. [Google Scholar] [CrossRef]
- Su, W.; Zhou, Z.; Jiang, F.; Chang, X.; Liu, Y.; Wang, S.; Kan, W.; Xiao, M.; Shao, M.; Peng, F.; et al. Iodobacter limnosediminis sp. nov., isolated from Arctic lake sediment. Int. J. Syst. Evol. Microbiol. 2013, 63, 1464–1470. [Google Scholar] [CrossRef]
- Iodobacter arcticus Srinivas et al. 2013; Names for Life, LLC: East Lansing, MI, USA, 2020. [CrossRef]
- Rao, S.S.S.N.; Manasa, P.; Begum, Z.; Sunil, B.; Sailaja, B.; Singh, S.K.; Prasad, S.V.S.; Shivaji, S. Iodobacter arcticus sp. nov., a psychrotolerant bacterium isolated from meltwater stream sediment of an Arctic glacier. Int. J. Syst. Evol. Microbiol. 2013, 63, 2800–2805. [Google Scholar] [CrossRef]
- Schloss, P.D.; Allen, H.K.; Klimowicz, A.K.; Mlot, C.; Gross, J.A.; Savengsuksa, S.; McEllin, J.; Clardy, J.; Ruess, R.W.; Handelsman, J. Psychrotrophic Strain of Janthinobacterium lividum from a Cold Alaskan Soil Produces Prodigiosin. DNA Cell Biol. 2010, 29, 533–541. [Google Scholar] [CrossRef]
- Pantanella, F.; Berlutti, F.; Passariello, C.; Sarli, S.; Morea, C.; Schippa, S. Violacein and biofilm production in Janthinobacterium lividum. J. Appl. Microbiol. 2007, 102, 992–999. [Google Scholar] [CrossRef]
- Lincoln, S.P.; Fermor, T.R.; Tindall, B.J. Janthinobacterium agaricidamnosum sp. nov., a soft rot pathogen of Agaricus bisporus. Int. J. Syst. Evol. Microbiol. 1999, 49, 1577–1589. [Google Scholar] [CrossRef] [PubMed]
- Avguštin, J.A.; Bertok, D.Ž.; Kostanjšek, R.; Avguštin, G. Isolation and characterization of a novel violacein-like pigment producing psychrotrophic bacterial species Janthinobacterium svalbardensis sp. nov. Antonie Leeuwenhoek 2013, 103, 763–769. [Google Scholar] [CrossRef]
- Hiraishi, A.; Shin, Y.K.; Sugiyama, J. Proposal to Reclassify Zoogloea ramigera IAM 12670 (P. R. Dugan 115) as Duganella zoogloeoides gen. nov., sp. nov. Int. J. Syst. Bacteriol. 1997, 47, 1249–1252. [Google Scholar] [CrossRef][Green Version]
- Whitman, W.B.; Rainey, F.; Kämpfer, P.; Trujillo, M.; Chun, J.; DeVos, P.; Hedlund, B.; Dedysh, S. Duganella. In Bergey’s Manual of Systematics of Archaea and Bacteria; Wiley: Hoboken, NJ, USA, 2015. [Google Scholar] [CrossRef]
- Li, W.-J.; Zhang, Y.-Q.; Park, D.-J.; Li, C.-T.; Xu, L.-H.; Kim, C.-J.; Jiang, C.-L. Duganella violaceinigra sp. nov., a novel mesophilic bacterium isolated from forest soil. Int. J. Syst. Evol. Microbiol. 2004, 54, 1811–1814. [Google Scholar] [CrossRef] [PubMed][Green Version]
- Kämpfer, P.; Wellner, S.; Lohse, K.; Martin, K.; Lodders, N. Duganella phyllosphaerae sp. nov., isolated from the leaf surface of Trifolium repens and proposal to reclassify Duganella violaceinigra into a novel genus as Pseudoduganella violceinigra gen. nov., comb. nov. Syst. Appl. Microbiol. 2012, 35, 19–23. [Google Scholar] [CrossRef]
- De Boer, W.; Leveau, J.H.J.; Kowalchuk, G.A.; Gunnewiek, P.J.A.K.; Abeln, E.C.A.; Figge, M.J.; Sjollema, K.; Janse, J.D.; Van Veen, J.A. Collimonas fungivorans gen. nov., sp. nov., a chitinolytic soil bacterium with the ability to grow on living fungal hyphae. Int. J. Syst. Evol. Microbiol. 2004, 54, 857–864. [Google Scholar] [CrossRef] [PubMed]
- Hakvåg, S.; Fjaervik, E.; Klinkenberg, G.; Borgos, S.E.F.; Josefsen, K.D.; Ellingsen, T.E.; Zotchev, S.B. Violacein-Producing Collimonas sp. from the Sea Surface Microlayer of Costal Waters in Trøndelag, Norway. Mar. Drugs 2009, 7, 576–588. [Google Scholar] [CrossRef] [PubMed]
- La Scola, B.; Birtles, R.J.; Mallet, M.-N.; Raoult, D. Massilia timonae gen. nov., sp. nov., Isolated from Blood of an Immunocompromised Patient with Cerebellar Lesions. J. Clin. Microbiol. 1998, 36, 2847–2852. [Google Scholar] [CrossRef] [PubMed]
- Whitman, W.B.; Rainey, F.; Kämpfer, P.; Trujillo, M.; Chun, J.; DeVos, P.; Hedlund, B.; Dedysh, S. Massilia. In Bergey’s Manual of Systematics of Archaea and Bacteria; Wiley: Hoboken, NJ, USA, 2015. [Google Scholar] [CrossRef]
- Wang, H.; Zhang, X.; Wang, S.; Zhao, B.; Lou, K.; Xing, X.-H. Massilia violaceinigra sp. nov., a novel purple-pigmented bacterium isolated from glacier permafrost. Int. J. Syst. Evol. Microbiol. 2018, 68, 2271–2278. [Google Scholar] [CrossRef] [PubMed]
- Yang, E.; Zhao, M.; Li, S.; Wang, Y.; Sun, L.; Liu, J.; Wang, W. Massilia atriviolacea sp. nov., a dark purple-pigmented bacterium isolated from soil. Int. J. Syst. Evol. Microbiol. 2019, 69, 2135–2141. [Google Scholar] [CrossRef]

| Properties | Study Cultures | ||||||
|---|---|---|---|---|---|---|---|
| JF4 | Chromobacterium [17,18,19,20,21,22,23,24,25,26,27,28,29,30] | Iodobacter [31,32,33,34,35,36] | Janthinobacterium [17,37,38,39,40,41] | Duganella [16,42,43,44] | Collimonas [45,46] | Massilia [47,48,49,50] | |
| pigment formation | + | + | + | + | + | + | + |
| Colonies: | |||||||
| round scalloped | + | - | - | - | - | ND | ND |
| round with a roller on the edge | + | - | - | - | - | ND | ND |
| colony profile | crater-shaped | ND | ND | ND | ND | ND | ND |
| surface of colonies | wavy | ND | ND | ND | ND | ND | ND |
| smooth | + | - | - | - | ND | ND | |
| rough | + | + | - | - | + | ND | ND |
| convex | + | - | - | + | + | ND | ND |
| structure | coarse-grained | ND | ND | ND | ND | ND | ND |
| oily consistency | - | + | + | - | - | ND | ND |
| viscous | + | - | - | - | + | ND | ND |
| root mean square diameter of colonies, mm | 1.93 | ND | 10 | ND | ND | ND | ND |
| Cell shape: | |||||||
| rod-shaped | + | + | + | + | + | + | + |
| globular bacteria | - | - | - | - | - | - | - |
| straight | + | + | + | + | + | + | - |
| slightly curved | + | - | - | + | + | + | - |
| Situated: | |||||||
| singly | + | + | + | + | ND | - | ND |
| in pairs | + | + | + | + | ND | + | ND |
| in chains | + | + | + | + | ND | - | ND |
| Gram stain | Gram- | Gram- | Gram- | Gram- | Gram- | Gram- | Gram- |
| dispute formation | - | - | - | - | - | - | - |
| motility | + | + | + | + | + | + | + |
| Relationship to O2: | |||||||
| obligate aerobic | + | - | - | + | + | + | + |
| microaerophilic | - | - | - | - | - | - | - |
| facultatively anaerobic | - | + | + | - | - | - | - |
| obligate anaerobic | - | - | - | - | - | - | - |
| growth ability with 4 °C | + | - | + | + | - | - | - |
| optimum growth temperature | 20–25 °C | 30–35 °C | 25 °C | 25 °C | 28–37 °C | 20–30 °C | ND |
| optimal pH | 7–8 | 7–8 | 4–5 | 7–8 | 7–7.5 | 6.5 | ND |
| growth at 1% NaCl | + | + | + | + | - | ND | + |
| growth at 3% NaCl | - | ND | - | - | ND | + | |
| growth at 4% NaCl | - | ND | - | - | - | ND | - |
| growth at 6% or more, NaCl | - | ND | - | - | - | ND | ND |
| requirements for growth factors | - | - | - | - | - | ND | ND |
| oxidase | - | + | - | + | + | + | - |
| catalase | + | + | ND | + | + | - or weak | + |
| indole | - | - | - | - | - | ND | ND |
| ureaza | - | ND | - | ND | + | ND | - |
| lecithinase | - | + | + | - | ND | ND | |
| lipase | - | - | - | - | + | + | ND |
| β-galactosidase | - | ND | - | ND | - | ND | |
| arginine dihydrolase | - | ND | ND | ND | - | ND | + |
| lysine decarboxylase | - | ND | - | ND | ND | ND | ND |
| ornithine decarboxylase | - | ND | - | ND | ND | ND | ND |
| tryptophanedaminase | - | ND | ND | ND | ND | ND | ND |
| acetoin formation (Voges–Proskauer reaction) | - | ND | ND | ND | ND | ND | ND |
| formation of ammonia from peptone | + | - | ND | + | ND | ND | ND |
| H2S formation | - | - | - | ND | - | ND | ND |
| phosphatase activity | + | ND | ND | + | ND | ND | ND |
| Hydrolysis: | |||||||
| starch | - | - | + | - | + | + | |
| casein | + | + | ND | + | + | ND | |
| gelatin | - | + | + | + | + | + | |
| Carbon utilization: | |||||||
| citrates | + | ND | ND | + | ND | ND | - |
| glycerin | + | - | - | ND | - | ND | ND |
| erythritol | - | ND | ND | ND | - | ND | ND |
| D-arabinose | - | ND | ND | ND | ND | ND | ND |
| L-arabinose | + | - | - | + | ND | ND | + |
| D-ribose | + | ND | ND | ND | ND | ND | ND |
| D-xylose | + | - | - | + | + | ND | + |
| L-xylose | - | ND | ND | ND | ND | ND | ND |
| D-adonitol | - | ND | ND | ND | ND | ND | ND |
| methyl-βD-xylopyranoside | - | ND | ND | ND | ND | ND | ND |
| D-galactose | + | - | - | + | + | ND | - |
| D-glucose | + | ND | ND | + | + | ND | - |
| D-fructose | + | ND | ND | + | - | ND | - |
| D-mannose | + | + | + | + | ND | ND | ND |
| D-sorbose | - | ND | ND | ND | ND | ND | ND |
| L-rhamnose | - | ND | ND | ND | ND | ND | + |
| dulcitol | - | ND | ND | ND | ND | ND | ND |
| inositol | + | ND | ND | + | ND | + | ND |
| D-mannitol | + | ND | ND | + | + | ND | ND |
| D-sorbitol | + | ND | ND | + | ND | ND | ND |
| methyl-αD-mannopyranoside | - | ND | ND | ND | ND | ND | ND |
| methyl-αD -glucopyranoside | - | ND | ND | ND | ND | ND | ND |
| N-cetylglucosamine | + | ND | ND | ND | + | ND | ND |
| amygdalin | - | ND | ND | ND | ND | ND | ND |
| arbutin | - | ND | ND | ND | ND | ND | ND |
| esculin (iron citrate) | + | - | - | ND | ND | ND | ND |
| salicin | - | - | - | ND | + | ND | ND |
| D-cellobiose | - | - | - | ND | + | ND | + |
| D-maltose | + | + | + | + | + | ND | + |
| D-lactose (bovine) | - | ND | ND | + | + | ND | + |
| D-melibioses | - | ND | ND | ND | ND | ND | ND |
| D-sucrose | + | - | - | + | ND | ND | - |
| D-trehalose | - | + | + | - | ND | + | ND |
| inulin | - | ND | ND | + | ND | ND | ND |
| D-melecytosis | - | ND | ND | - | ND | ND | ND |
| D-raffinose | - | ND | ND | - | ND | ND | ND |
| glycogen | - | ND | ND | ND | ND | ND | ND |
| xylitol | + | ND | ND | ND | ND | ND | ND |
| gentiobioses | - | ND | ND | ND | ND | ND | ND |
| D-turanose | - | ND | ND | ND | ND | ND | ND |
| D-lyxoses | + | ND | ND | ND | ND | ND | ND |
| D-tagatose | - | ND | ND | ND | ND | ND | ND |
| D-fucose | - | ND | ND | ND | ND | ND | ND |
| L-fucose | - | ND | ND | ND | ND | ND | ND |
| D-arabit | + | ND | ND | ND | ND | ND | ND |
| L-arabit | - | ND | ND | ND | ND | ND | ND |
| potassium gluconate | - | ND | ND | ND | ND | ND | ND |
| potassium 2-ketogluconate | + | ND | ND | ND | ND | ND | ND |
| potassium 5-ketogluconate | - | ND | ND | ND | ND | ND | ND |
| № ∏/∏ | Test Cultures | JF4 |
|---|---|---|
| 1. | Pseudomonas aeruginosa ML4262 | – |
| 2. | P. putida KT2442 | + |
| 3. | P. protegens 38a | – |
| 4. | P. chlororaphis PCL1391 | – |
| 5. | P. fluorescens B 849 | + |
| 6. | P. caryophylli BKM 1290 | – |
| 7. | Escherichia coli S | – |
| 8. | E. coli B | – |
| 9. | Erwinia herbicola ATCC 27155 | – |
| 10. | Alcaligenes faecalis BKM 1518 | – |
| 11. | Bacillus cereus GA5T | – |
| 12. | B. weihnestephanensis KBA4 | – |
| 13. | B. subtilis | – |
| 14. | B. shaericus BKM B509-1 | – |
| 15. | B. thuringiensis ATCC 35646 | – |
| 16. | B. flexsus | – |
| 17. | Micrococcus luteus B1891 | + |
| 18. | M. roseus B1236 | – |
| 19. | St35 | – |
| 20. | Arthrobacter sp. B52 | – |
| 21. | Deinococcus radiodurans | – |
| 22. | Achromobacter ruhlandii B-1330 | + |
| Antibiotic | Concentration | JF4 |
|---|---|---|
| Amikacin | 30 μg | +++ |
| Amoxicillin | 20 μg | ++ |
| Ampicillin | 10 μg | – |
| Bacitracin | 10 units | + |
| Bacitracin | 0.04 units | – |
| Benzylpenicillin | 10 units | – |
| Vancomycin | 30 μg | + |
| Gentamicin | 10 μg | + |
| Gentamicin | 120 μg | +++ |
| Imipenem | 10 μg | – |
| Kanamycin | 30 μg | ++ |
| Carbenicillin | 25 μg | ++ |
| Carbenicillin | 100 μg | ++ |
| Levomycin | 30 μg | ++ |
| Lincomycin | 15 μg | + |
| Meropenem | 10 μg | – |
| Nalidixic acid | 30 μg | +++ |
| Neomycin | 30 μg | + |
| Nystatin | 80 units | + |
| Novobiocin | + | |
| Norfloxacin | 10 μg | + |
| Oxacillin | 10 μg | – |
| Oxacillin | 1 μg | – |
| Ofloxacin | 5 μg | +++ |
| Piperacillin | 100 μg | +++ |
| Polimxin | 300 units | + |
| Rifampicin | 5 μg | + |
| Streptomycin | 30 μg | + |
| Streptomycin | 300 μg | + + |
| Tetracycline | 30 μg | + |
| Tobralicin | 10 μg | +++ |
| Trimethoprim/Sulfamethoxazole | 1.25/23.75 μg | +++ |
| Furazolidone | 300 μg | +++ |
| Cefazolin | 30 μg | – |
| Cefotaxin | 30 μg | +++ |
| Ceftazidine | 30 μg | – |
| Ciprofloxacin | 5 μg | +++ |
| Erythromycin | 15 μg | + |
Publisher’s Note: MDPI stays neutral with regard to jurisdictional claims in published maps and institutional affiliations. |
© 2021 by the authors. Licensee MDPI, Basel, Switzerland. This article is an open access article distributed under the terms and conditions of the Creative Commons Attribution (CC BY) license (http://creativecommons.org/licenses/by/4.0/).
Share and Cite
Lyakhovchenko, N.S.; Abashina, T.N.; Polivtseva, V.N.; Senchenkov, V.Y.; Pribylov, D.A.; Chepurina, A.A.; Nikishin, I.A.; Avakova, A.A.; Goyanov, M.A.; Gubina, E.D.; et al. A Blue-Purple Pigment-Producing Bacterium Isolated from the Vezelka River in the City of Belgorod. Microorganisms 2021, 9, 102. https://doi.org/10.3390/microorganisms9010102
Lyakhovchenko NS, Abashina TN, Polivtseva VN, Senchenkov VY, Pribylov DA, Chepurina AA, Nikishin IA, Avakova AA, Goyanov MA, Gubina ED, et al. A Blue-Purple Pigment-Producing Bacterium Isolated from the Vezelka River in the City of Belgorod. Microorganisms. 2021; 9(1):102. https://doi.org/10.3390/microorganisms9010102
Chicago/Turabian StyleLyakhovchenko, Nikita S., Tatiana N. Abashina, Valentina N. Polivtseva, Vladislav Yu. Senchenkov, Daniil A. Pribylov, Anna A. Chepurina, Ilja A. Nikishin, Alina A. Avakova, Michael A. Goyanov, Elizaveta D. Gubina, and et al. 2021. "A Blue-Purple Pigment-Producing Bacterium Isolated from the Vezelka River in the City of Belgorod" Microorganisms 9, no. 1: 102. https://doi.org/10.3390/microorganisms9010102
APA StyleLyakhovchenko, N. S., Abashina, T. N., Polivtseva, V. N., Senchenkov, V. Y., Pribylov, D. A., Chepurina, A. A., Nikishin, I. A., Avakova, A. A., Goyanov, M. A., Gubina, E. D., Churikova, D. A., Sirotin, A. A., Suzina, N. E., & Solyanikova, I. P. (2021). A Blue-Purple Pigment-Producing Bacterium Isolated from the Vezelka River in the City of Belgorod. Microorganisms, 9(1), 102. https://doi.org/10.3390/microorganisms9010102

